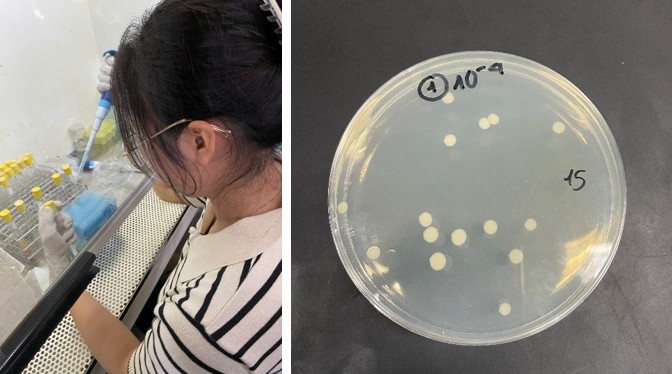

Nuôi trồng thủy sản được xác định là một trong những ngành kinh tế mũi nhọn của Việt Nam, với nhu cầu ngày càng cao về nguồn nhân lực chất lượng, am hiểu thực tiễn sản xuất và công nghệ hiện đại. Trên cơ sở đó, Ngành Nuôi trồng thủy sản – Chương trình Minh Phú – NTU được xây dựng theo định hướng thực hành, gắn đào tạo với doanh nghiệp và đáp ứng yêu cầu hội nhập quốc tế.
Thực tập quốc tế – Điểm nhấn khác biệt của chương trình
Từ tháng 12/2025 đến tháng 01/2026, 05 sinh viên ngành Nuôi trồng thủy sản – Chương trình Minh Phú – NTU, lớp 64.NTTS-MP đã tham gia thực tập giáo trình “Kỹ thuật nuôi thủy sản” tại Trường Đại học Chiang Mai (Thái Lan).
Chương trình thực tập quốc tế đã mang đến cho sinh viên cơ hội học tập, rèn luyện kỹ năng thực hành và giao lưu học thuật trong môi trường đào tạo quốc tế, góp phần nâng cao năng lực chuyên môn và khả năng hội nhập.

Sinh viên vệ sinh và cải tạo ao nuôi
Học từ ao nuôi đến phòng thí nghiệm hiện đại
Trong suốt quá trình thực tập, sinh viên được trực tiếp tham gia các mô hình nuôi thủy sản thực tế, đặc biệt là mô hình nuôi thương phẩm cá rô phi. Sinh viên được hướng dẫn và thực hành các nội dung chuyên môn như:
- Thực hành cải tạo ao, chuẩn bị nước và quản lý môi trường nuôi
• Hướng dẫn cho ăn, điều chỉnh khẩu phần và theo dõi tăng trưởng
• Đo các chỉ tiêu môi trường như nhiệt độ, pH
• Tiếp cận các kỹ thuật sinh học hiện đại:
– Kiểm tra enzyme trong ruột cá
– Tách DNA từ máu cá, RNA từ ruột cá
– Phân lập lợi khuẩn phục vụ nuôi trồng bền vững

Sinh viên thực hành tách DNA/RNA trong phòng thí nghiệm
Tiếp cận kỹ thuật nuôi tôm tiên tiến
Song song với mô hình nuôi cá rô phi, sinh viên được thực tập kỹ thuật nuôi thương phẩm tôm càng xanh với các nội dung như:
- Chuẩn bị ao nuôi và xử lý nước
- Quản lý thức ăn, theo dõi các yếu tố môi trường
- Đánh giá tình trạng sức khỏe vật nuôi
Thông qua các hoạt động này, sinh viên được củng cố kiến thức chuyên môn và nâng cao kỹ năng thực hành trong nuôi trồng thủy sản.

Tôm càng xanh và cá rô phi
Nuôi trồng thủy sản gắn với công nghệ sinh học
Chương trình Minh Phú không chỉ trang bị cho sinh viên kỹ năng “biết nuôi”, mà còn giúp sinh viên hiểu sâu bản chất sinh học của đối tượng nuôi. Từ đó, sinh viên có khả năng:
- Ứng dụng công nghệ sinh học vào nuôi trồng thủy sản
- Tiếp cận các mô hình nuôi an toàn sinh học, bền vững
- Đáp ứng nhu cầu tuyển dụng ngày càng cao của doanh nghiệp trong và ngoài nước
Học cùng doanh nghiệp – Mở rộng cơ hội nghề nghiệp
Là chương trình đào tạo đặt hàng của Tập đoàn Thủy sản Minh Phú – Doanh nghiệp Thủy sản hàng đầu Việt Nam, sinh viên được định hướng nghề nghiệp sớm, tăng cường kỹ năng thực hành, nâng cao năng lực làm việc trong môi trường quốc tế, đồng thời mở rộng cơ hội thực tập và việc làm sau khi tốt nghiệp.
Sinh viên tốt nghiệp có thể làm việc tại các doanh nghiệp nuôi trồng thủy sản, trung tâm nghiên cứu, doanh nghiệp FDI hoặc khởi nghiệp trong lĩnh vực thủy sản công nghệ cao.
Sinh viên kiểm tra enzyme và phân lập lợi khuẩn
Chọn ngành Nuôi trồng Thủy sản chương trình Minh Phú _NTU – Chọn tương lai bền vững
Với định hướng đào tạo gắn lý thuyết với thực tiễn, kết nối chặt chẽ với doanh nghiệp và mở rộng cơ hội trải nghiệm quốc tế, Ngành Nuôi trồng thủy sản – Chương trình Minh Phú, Trường Đại học Nha Trang là lựa chọn phù hợp cho những bạn mong muốn phát triển sự nghiệp bền vững cùng ngành thủy sản Việt Nam.
Tin bài: Trần Văn Phước & Mai Như Thủy